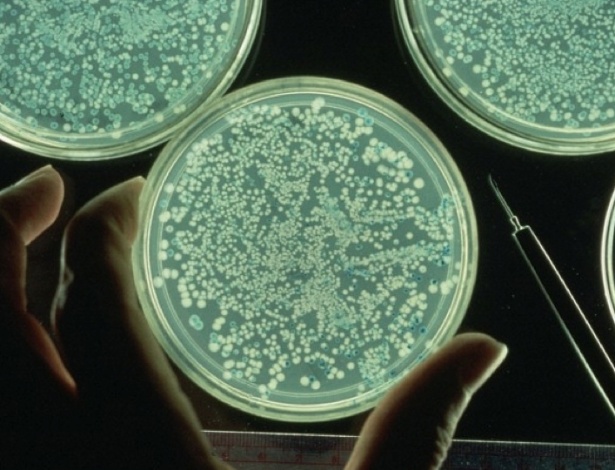

iStock
iStock O Enem 2016 (Exame Nacional do Ensino Médio) será realizado só em novembro, mas os estudantes já precisam aumentar o ritmo de estudos. Pensando nisso, o UOL Educação e o Sistema Ari de Sá (SAS) prepararam um conteúdo especial com alguns dos temas que você precisa saber.
Bons estudos!